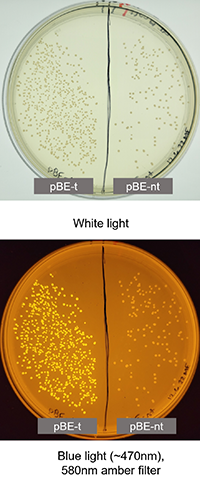

High School Students Learn the Basics of Base Editing to Cure “GFP-itis”
Outreach program introduces local students to genome engineering and a career in science
Genome editing is used to modify the genes of living organisms to elicit certain traits, such as climate-resilient crops or treating human disease at the genetic level. It has become increasingly popular in agriculture, medicine and basic science research over the past decade, and will continue to be relevant and utilized well into the future. Given this prevalence, researchers at the University of California San Diego have started an outreach program that introduces genome-editing technologies to high school students.
Assistant Professor of Chemistry and Biochemistry Alexis Komor, and Ph.D. candidates Mallory Evanoff and Carlos Vasquez, designed the Genome Editing Technologies Program as a way to educate students on base-editing technologies, expose them to scientists from diverse backgrounds and invite questions about college, professional development, and the everyday life of a graduate student or faculty member within academia. The program is detailed in April 20 issue of The CRISPR Journal.
Base editors enable scientists to introduce point mutations at targeted sites in the genome of living cells with high efficiency and precision and, thus, have the therapeutic potential to treat thousands of human genetic disorders. Proof-of-concept studies have already demonstrated this technology’s potential in cell therapies and in treating progeria, sickle cell disease and liver diseases.
“As we were testing out some of these tools, we asked ourselves, how do we make base editors accessible to high schoolers? How do we make this process really visible?” said Evanoff.
After 24 hours, students are able to see if the "cure" worked using a blue light to show the green fluorescence (bottom).
After 24 hours, students are able to see if the "cure" worked using a blue light to show the green fluorescence (bottom).
Komor’s team generated a base-editing reporter system using E. coli bacteria. In this system, base-editing activity results in the expression of green fluorescent protein (GFP). The team installed a mutation in the bacterium’s GFP gene to remove its fluorescence. To emphasize the connection to genetic diseases, this phenotype is called “GFP-itis,” and students are tasked with “curing” the bacteria. Using base-editing technology, students correct the mutation back to wild-type, resulting in bacterial cells that fluoresce green.
The program happens over three days, creating a more meaningful partnership with the school and building a better foundation of trust with the students. “We wanted the students to get to know us better and feel comfortable asking questions about a career in STEM,” said Komor. “A popular question is simply, ‘How do I get into undergraduate research?’ One of the students in the first school we visited, Sage Creek High School, is actually an undergraduate researcher in our lab now.”
That student is Preety Iyer, a first-year human biology major, who recalled Komor’s visit to her high school as “an amazing opportunity to get hands-on experience with gene-editing technology. It seemed like an intangible concept to me when I was learning about it in my biology classes. Being walked through the entire process and being able to do it myself strengthened my understanding of DNA and gene editing.”
 Preety Iyer was a student at Sage Creek High School, where the Komor lab did the gene-editing activity. Now Iyer works in Komor's lab.
Preety Iyer was a student at Sage Creek High School, where the Komor lab did the gene-editing activity. Now Iyer works in Komor's lab.
Iyer plans to become a doctor working with patients who have rare genetic disorders, and she’s excited to gain more valuable hands-on experience in Komor’s lab: “I’ve been able to use equipment and practice techniques, like flow cytometry and plasmid preparation, that other students don’t get to use until later in their academic careers.”
So far, the Genome Editing Technologies Program has visited three local high schools. The schools have had well-developed science classes and much of the equipment needed to run the experiment. The majority of students had also heard of or learned about genome engineering before. Now that Komor’s team has run the program a few times and solicited feedback from students, they hope to expand to schools without such robust science programming.
“My high school background in science wasn’t strong in large part because of the lack of mentorship,” said Vasquez. “It’s important to us to reach students who may not have even considered a career in STEM or medicine. To look in their eyes and instill confidence, to show we believe in them — having someone like that when I was in high school would have made a world of difference.”
The make the experiment as accessible as possible, the team has simplified the base-editing experiment and provides all the necessary equipment. Accessibility also means making the program available to other institutions that may want to implement something similar. Interested scientists or instructors can order plasmid materials from AddGene, a worldwide nonprofit plasmid repository. These plasmids are the DNA needed to make the GFP-itis cells, as well the plasmids needed to as "cure" GFP-itis.
The goal of the program is not only to make base editing accessible to high school students, but also to encourage critical thinking and reflect on base editing in social and cultural contexts. Komor’s team asked students to think about the difference between a disease and a trait and to consider the implications of germline genome editing, in which edits are inherited by all future descendants of the edited individual, regardless of whether those descendants consent to the procedure.
“The ethical discussion is what hits a home run with the students,” said Vasquez. “They’ll be responsible for future gene-editing policies. It’s interesting to see them thinking about the ethical side of science.”
“We’ve had some really good discussions about what is a disease and what is a trait,” stated Evanoff. “If we have the ability to make genetic-disease corrections, who will be able to afford those treatments? Where does the equitability lie in this technology? We don't have the answers to that. I say to students, ‘That's going to be your job to figure out!’”
This research was supported by the National Science Foundation (MCB-2048207), the National Institute of General Medical Sciences (T32 GM007240-41), the National Institute of Health (T32 GM112584), the Howard Hughes Medical Institute (GT13672 and the Gilliam Fellowship Program) and the National Academies of Sciences, Engineering, and Medicine Ford Foundation Predoctoral Fellowship Program.
Publication: Carlos A. Vasquez, et al, Curing “GFP-itis” in Bacteria with Base Editors: Development of a Genome Editing Science Program Implemented with High School Biology Students, CRISPR Journal (2023) DOI: 10.1089/crispr.2023.0002
Original Story Source: UC San Diego

 Alerts Sign-up
Alerts Sign-up